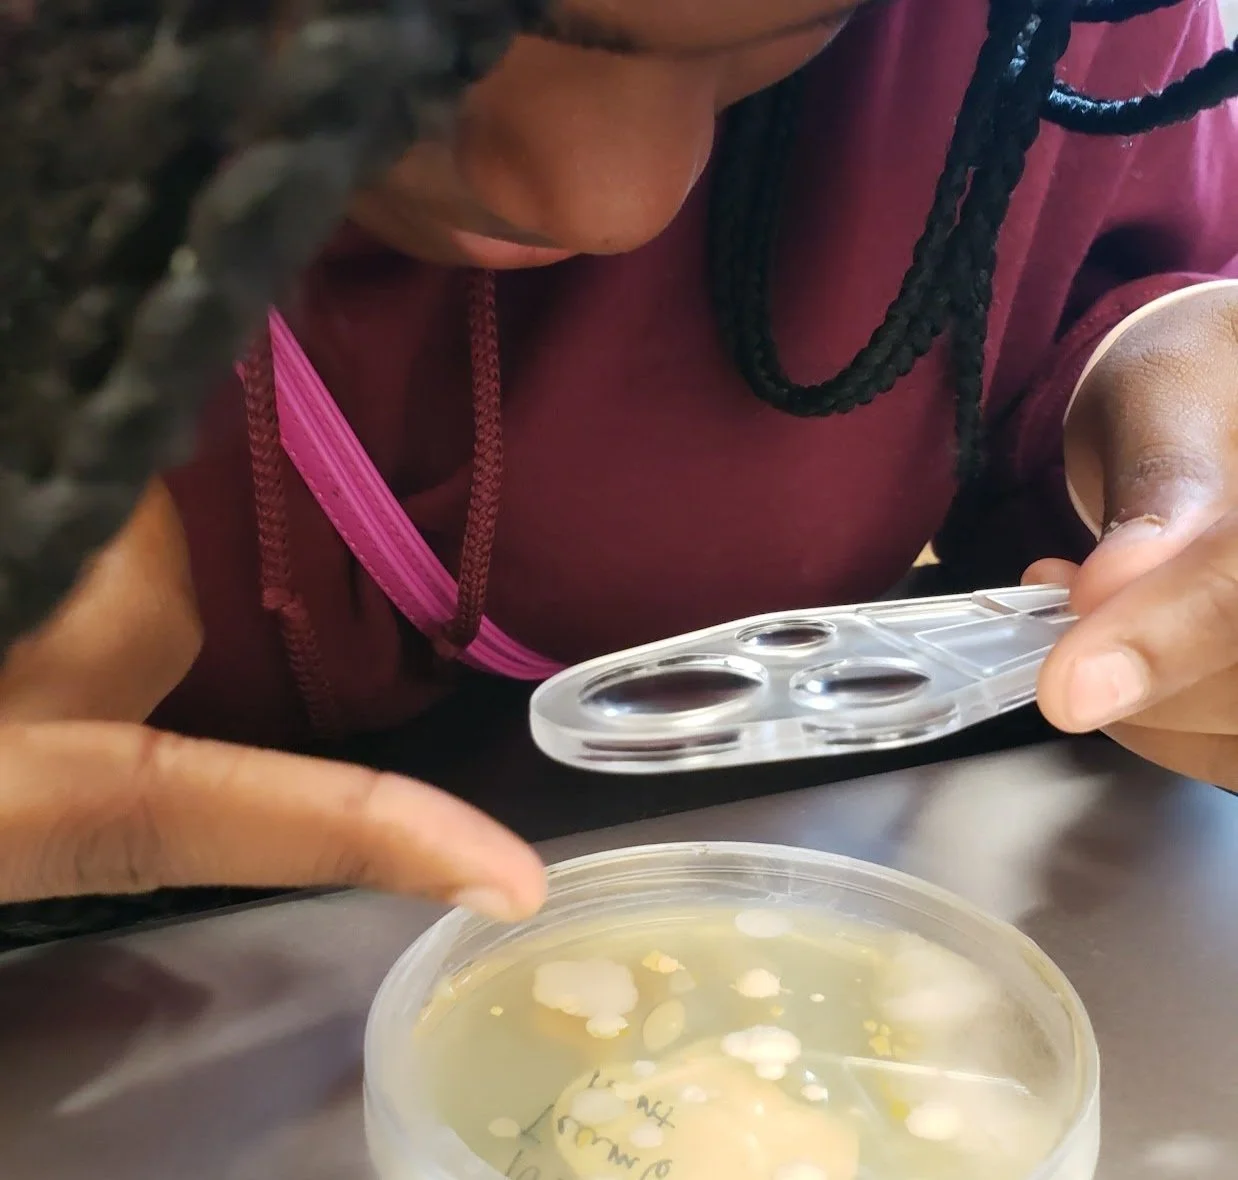

Small Wonders
Think small! The Small Wonders program teaches students about microbes, the single-celled organisms that live in the air, water, soil, and even inside our own bodies. During the five days of the program, students will learn about lenses and microscopy, take microbial samples from their classroom, grow a model of an algae bloom, build a microbial ecosystem, and set up experiments they can continue to observe in their classrooms for weeks and months after the program’s end.
Small organisms are a big adventure!
While the BioEYES Educator will lead the program across all five days, the students are the scientists who actually set up the hands-on experiments by choosing and preparing all the samples, exploring their surroundings, hypothesizing about results, and observing as their experiments progress. They will use real laboratory materials, such as pipettes, agar plates, microscopes, parafilm, and sample swabs. By the end of the week, they’ll be able to observe the results of one experiment and have prepared two others that they will continue to observe with their teacher after the program’s conclusion. Along the way, they will touch on subjects including biology, ecology, evolutionary niches, optics, and more!
Growing microbial samples
What sort of microbes are around us right now, and how can we study them? Each group of students will take microbial samples from sources they choose within their classroom — the floor, their chairs, the doorknob, whatever! — and grow them in Petri dishes containing an agar-based growth medium. This solid growth medium allows microbial colonies to separate out from each other and form individual colonies that can help identify the specific kind of microbes that were sampled. The students hypothesize about which of their sources will result in the most growth, the least growth, and the most different kinds of growth.
Algae blooms
Algae are various types of plant-like, photosynthetic organisms, many of which are single-celled. Despite being so small, though, algae actually creates around half of the world’s oxygen! In the classroom, students will set up algae cultures they will observe over the next several weeks to see how they are affected by different conditions, including how introducing too many nutrients into an ecosystem can result in an overgrowth called an algae bloom.

Winogradsky columns
Outside of a laboratory, microbes don’t usually grow in neatly separated colonies. Instead, they form part of an ecosystem that contains many kinds of interacting and interrelated organisms. Using soil, water, and a variety of nutrition sources, students will build a Winogradsky column to model these microbial ecosystems. Over the months following the program, the microbes in each column will grow and settle out into layers based upon their differing needs and ecological niches, which the students can observe to determine what sorts of microbes are present.
Microscopy
When people think about studying very small objects like microbes, their first thought is usually “Microscopes!” Students experiment with hand lenses to learn the basic properties of magnification, focusing, and combining lenses, before trying out actual miniature microscopes they can use to explore their surroundings close up.
